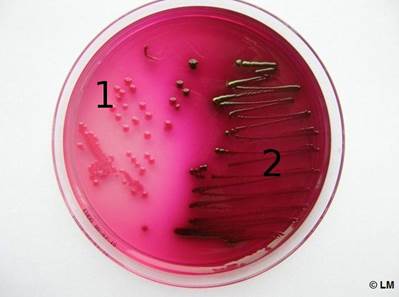

Главная страница Случайная страница
КАТЕГОРИИ:
АвтомобилиАстрономияБиологияГеографияДом и садДругие языкиДругоеИнформатикаИсторияКультураЛитератураЛогикаМатематикаМедицинаМеталлургияМеханикаОбразованиеОхрана трудаПедагогикаПолитикаПравоПсихологияРелигияРиторикаСоциологияСпортСтроительствоТехнологияТуризмФизикаФилософияФинансыХимияЧерчениеЭкологияЭкономикаЭлектроника
Выберите правильный ответ
|
|
1. К семейству Enterobacteriaceae относятся:
Pseudomonas aeruginosa
Shigella flexneri
Bifidobacterium bifidum
Staphylococcus aureus
Bacillus cereus
2. Возбудитель холеры относится к семейству:
Enterobacteriaceae
Vibrionaceae
Clostridiaceae
Brucellaceae
Bacillaceae
3. Выберите верно указанные морфологические признаки Vibrio cholerae:
грамоположительные палочки, окруженные капсулой
грамположительные спорообразующие палочки
грамположительные палочки с утолщениями на концах
грамотрицательные подвижные изогнутые палочки
грамотрицательные неподвижные изогнутые палочки
4. Как приготовить микропрепарат для микроскопии, чтобы выявить подвижность холерного вибриона?
приготовить фиксированный препарат и окрасить по Граму
приготовить фиксированный препарат и окрасить по Цилю-Нильсену
приготовить фиксированный препарат, но не окрашивать
приготовить препарат „раздавленная капля”
приготовить фиксированный препарат и окрасить по Нейссеру
5. Для выделения чистой культуры Vibrio cholerae, как правило, используют:
желточно-солевой агар
агар с желчью
кровяной агар
кровяной агар с теллуритом калия
щелочной МПА
6. Выберите группоспецифический антиген Vibrio cholerae:
О-антиген
белок А
капсульный антиген
жгутиковый Н-антиген
Vi-антиген
7. Бактерии - представители семейства Enterobacteriaceae морфологически являются:
грамположительными кокками
грамположительными палочками
грамотрицательными кокками
грамотрицательными палочками
спирохетами
8. Основным методом лабораторной диагностики пищевых токсикоинфекций бактериальной этиологии является:
бактериологический метод
бактериоскопический метод
биологический метод
молекулярно-генетический метод
метод кожно-аллергических проб
9. Какой из перечисленных микроорганизмов является продуцентом токсина Шига:
Salmonella enterica
Shigella dysenteriae
Campylobacter fetus
Staphylococcus aureus
Clostridium botulinum
10. Выберите фактор патогенности, характерный для холерного вибриона:
энтеротоксин
токсин Шига
плазмокоагулаза
белок А
тетаноспазмин
11. Какой из перечисленных микроорганизмов является возбудителем брюшного тифа:
Salmonella enterica серовар Typhimurium
Shigella flexneri
Escherichia coli
Salmonella enterica серовар Typhi
Staphylococcus aureus
12. Микроорганизмы рода Shigella вызывают:
брюшной тиф
газовую гангрену
бактериальную дизентерию
псевдомембранозный колит
холеру
13. Выберите правильные утверждения, характеризующие LT токсин кишечных палочек:
является гемолизином
является белковым эндотоксином
относится к классу нейротоксинов
нарушает процессы мембранного транспорта ионов
ингибирует биосинтез белка
14. Какой из перечисленных микроорганизмов неподвижен:
Salmonella enterica серовар Paratyphi A
Vibrio cholerae
Helicobacter pylori
Shigella flexneri
Salmonella enterica серовар Typhi
15. Классификация Кауфмана-Уайта подразумевает:
деление сальмонелл на серогруппы по строению Н-антигена.
деление шигелл на серогруппы по строению О-антигена.
деление сальмонелл на серогруппы по строению О-антигена и на серовары по строению Н-антигена.
деление сальмонелл на серогруппы по строению К-антигена и на серовары по строению Н-антигена.
деление шигелл на серогруппы по строению К-антигена.
16. Какой из микроорганизмов является возбудителем пищевых интоксикаций:
Clostridium botulinum
Salmonella enterica
Shigella flexneri
Escherichia coli
Yersinia enterocolitica
17. Основным исследуемым материалом при брюшном тифе на 1-й неделе заболевания является:
кровь
промывные воды желудка
сыворотка крови
испражнения
желчь
18. Какую питательную среду используют для выделения гемокультуры при диагностике брюшного тифа и паратифов на предварительном этапе:
мясо-пептонный агар
среду Раппопорт
висмут-сульфит агар
среду Эндо
желточно-солевой агар
19. Какое биохимическое свойство характерно для Salmonella Typhi:
образование сероводорода
ферментация лактозы
ферментация глюкозы с образованием кислоты и газа
утилизация цитрата
продукция уреазы
20. Бактерии рода Salmonella на среде Эндо образуют:
лактозопозитивные колонии с металлическим блеском
ползучий рост
колонии, окруженные зоной помутнения
лактозонегативные колонии
колонии, окруженные зоной гемолиза
21. Какую серологическую реакцию проводят для диагностики брюшного тифа и паратифов:
Видаля
Асколи
Хеддлсона
Вассермана
Оухтерлони
22. При брюшном тифе реакция Видаля будет положительной:
только на 1-й неделе заболевания
со 2-й недели заболевания и далее
во всех периодах заболевания
в инкубационном периоде
в продромальном периоде
23. Какая серологическая реакция используется для серотипирования чистых культур сальмонелл:
иммуноблоттинг
реакция кольцепреципитации
реакция связывания комплемента
реакция агглютинации на стекле
реакция иммунного гемолиза
24. Каким из перечисленных свойств обладает холерный вибрион:
является перитрихом
окрашивается грамположительно
образует споры
является изогнутой палочкой
является облигатным анаэробом
25. Какое из перечисленных свойств характерно для холерного вибриона:
рост на щелочных питательных средах
отрицательный оксидазный тест
способность к продукции сероводорода
неподвижность
способность к продукции уреазы
26. К какой группе факторов патогенности относится холероген:
факторы адгезии и колонизации
антифагоцитарные факторы
факторы инвазии
экзотоксины
эндотоксины
27. Каков механизм действия холерогена:
подавляет синтез белка на рибосомах
нарушает целостность ЦПМ
необратимо активирует аденилатциклазную систему
блокирует передачу нервных импульсов
вызывает активацию комплемента
28. Токсин Шига является:
эндотоксином
экзотоксином
суперантигеном
анатоксином
фактором адгезии
29. Выберите изображение соответствующее E. coli (окраска по Граму)
 +
+




30. Выберите изображение соответствующее C. botulinum (окраска по Граму)
 +?
+?




31. Выберите изображение соответствующее S. aureus (окраска по Граму)
 +
+




32. На каком секторе чашки Петри со средой Эндо растет культура E. coli Lac+?
сектор 1
сектор 2
на обоих секторах
ни на одном
представленная среда не является средой Эндо
33. Антитела к какому антигену свидетельствуют о бактерионосительстве после перенесенного брюшного тифа?
Vi-антиген
О-антиген
H-антиген
Белок А
Шига-токсин
34. Каков механизм действия токсина Шига:
подавляет синтез белка на рибосомах
нарушает целостность ЦПМ
необратимо активирует аденилатциклазную систему
блокирует передачу нервных импульсов
вызывает активацию комплемента
35. Каков механизм действия стафилококкового энтеротоксина:
подавляет синтез белка на рибосомах
нарушает целостность ЦПМ
необратимо активирует аденилатциклазную систему
блокирует передачу нервных импульсов
вызывает поликлональную активацию Т-лимфоцитов
36. Основным методом лабораторной диагностики пищевых интоксикаций бактериальной этиологии является:
бактериологический метод
бактериоскопический метод
серологический метод
молекулярно-генетический метод
метод кожно-аллергических проб
37. Каков механизм действия ботулинического токсина:
подавляет синтез белка на рибосомах
нарушает целостность ЦПМ
необратимо активирует аденилатциклазу
блокирует передачу нервных импульсов
вызывает поликлональную активацию Т-лимфоцитов
38. Какой тип взаимодействия с клетками эпителия кишечника характерен для сальмонелл?
неинвазивный, энтеротоксигенный
ограничено инвазивный и энтеротоксигенный, цитотоксичный
высоко инвазивный, цитотоксичный
инвазивный с генерализацией процесса
неинвазивный, неэнтеротоксигенный
39. Какой тип взаимодействия с клетками эпителия кишечника характерен для шигелл и ЭИКП?
колонизация поверхности эпителиоцитов с синтезом энтеротоксинов
реорганизация цитоскелета апикальной части эпителиоцитов с образованием " пьедесталов"
инвазия в эпителиоциты и межклеточное распространение
инвазия сквозь эпителий с минимальным его повреждением
образование агрегатов и биоплёнок на поверхности эпителиоцитов
40. Какой тип взаимодействия с клетками эпителия кишечника характерен для холерного вибриона и ЭТКП?
колонизация поверхности эпителиоцитов с синтезом энтеротоксинов
реорганизация цитоскелета апикальной части эпителиоцитов с образованием " пьедесталов"
инвазия в эпителиоциты и межклеточное распространение
инвазия сквозь эпителий с минимальным его повреждением
образование агрегатов и биоплёнок на поверхности эпителиоцитов
41. Какой тип взаимодействия с клетками эпителия кишечника характерен для ЭПКП?
колонизация поверхности эпителиоцитов с синтезом энтеротоксинов
реорганизация цитоскелета апикальной части эпителиоцитов с образованием " пьедесталов"
инвазия в эпителиоциты и межклеточное распространение
инвазия сквозь эпителий с минимальным его повреждением
образование агрегатов и биоплёнок на поверхности эпителиоцитов
42. Какой тип взаимодействия с клетками эпителия кишечника характерен для сальмонелл и иерсиний?
колонизация поверхности эпителиоцитов с синтезом энтеротоксинов
реорганизация цитоскелета апикальной части эпителиоцитов с образованием " пьедесталов"
инвазия в эпителиоциты и межклеточное распространение
инвазия сквозь эпителий с минимальным его повреждением
образование агрегатов и биоплёнок на поверхности эпителиоцитов
43. Энтеропатогенные иерсинии по отношению к температуре принадлежат к группе:
психрофилов
термофилов
мезофилов
микроаэрофилов
ацидофилов
44. Кампилобактерии представляют собой:
грамположительные палочки с обрубленными концами
неподвижные грамотрицательные палочки
подвижные спиралевидные грамотрицательные палочки
спорообразующие грамположительные палочки
грамотрицательные кокки
45. Одним из важнейших ферментов патогенности Helicobacter pylori является:
гиалуронидаза
ДНКаза
плазмокоагулаза
уреаза
нейраминидаза
46. Helicobacter pylori может вызывать у человека:
энтероколит
неспецифический язвенный колит
псевдомембранозный колит
язвенную болезнь желудка и 12-перстной кишки
пневмонию
47. Активную профилактику брюшного тифа проводят:
живой вакциной?
иммуноглобулином
анатоксином
корпускулярной вакциной, обогащенной Vi-антигеном
рекомбинантной вакциной
48. Какой иммунитет формируется после перенесённой холеры:
антитоксический, антибактериальный, типоспецифический
противовирусный типоспецифический
только антибактериальный
только антитоксический
нестерильный
49. Определение серогруппы диареегенных эшерихий проводят с использованием адсорбированных сывороток:
О или сочетание ОК
сочетание КН
Н
сочетание ОН
Vi
50. Выберите изображение пробирки со скошенным агаром (среда Клиглера)соответствующее росту S. typhi

А
Б
В
Г
Д +?
51. Выберите изображение пробирки со скошенным агаром (среда Клиглера)соответствующее росту E. coli

А
Б
В
Г
Д
52. Возбудитель кишечного иерсиниоза относится к семейству:
Enterobacteriaceae
Vibrionaceae
Staphylococcaceae
Brucellaceae
Bacillaceae
53. На современном этапе холера вызывается чаще всего биоваром Vibrio cholerae:
Классическим
Эль-Тор
Албенсис
НАГ-вибрионами
Бенгал
54. Выберите главный фактор патогенности Vibrio cholerae:
гистотоксин
IgA-протеаза
капсула
термостабильный энтеротоксин
термолабильный энтеротоксин
55. Холероген по химической природе является:
углеводом
гликолипидом
белком с АВ5 структурой
липополисахаридом
нуклеиновой кислотой
56. Холерный токсин нарушает в клетках макроорганизма активность:
топоизомеразы
ДНК-полимеразы
фактора элонгации 2
фосфолипазы С
аденилатциклазной системы
57. Механизм действия холерного токсина заключается в:
АДФ-рибозилировании G белка
поликлональной активации Т-лимфоцитов
АДФ-рибозилировании фактора элонгации 2
расщепление синаптобревина
гликозидазном взаимодействии с 28S рРНК
58. Холерный токсин и LT-токсин ЭТКП по механизму действия на клетку-мишень являются:
активаторами аденилатциклазной системы
ингибиторами синтеза белка
блокаторами передачи нервного импульса
эксфолиативными токсинами
порообразующими токсинами
59. Основной механизм передачи холеры:
трансмиссивный
половой
фекально-оральный
воздушно-капельный
вертикальный
60. Причина диареи при холере:
воспаление слизистой оболочки кишечника
воздействие липополисахарида на стенку кишечника
воздействие экзотоксина на эпителиоциты тонкого кишечника
повреждение сосудов слизистой оболочки кишечника
воздействие экзотоксина на эпителиоциты толстого кишечника
61. Механизм диареи при холере:
нарушение всасывания воды в толстом кишечнике
повышенное осмотическое давление в кишечнике
избыточная секреция воды в тонком кишечнике за счёт дизрегуляции транспорта ионов
повышение проницаемости кровеносных сосудов
воспалительная реакция в толстом кишечнике
62. Диарея при холере:
инвазивная
осмотическая
секреторная
комбинированная
нейроэндокринная
63. Холерный вибрион паразитирует и размножается:
в кровеносном русле
в желчевыводящих путях
в подслизистом слое кишечника
на слизистой и в просвете тонкого кишечника
в желудке
64. В патогенезе холеры ведущим фактором является:
интоксикация, обусловленная массивной бактериемией
действие экзотоксина на эпителиоциты тонкого кишечника
проникновение холерных вибрионов через гематоэнцефалический барьер
способность вибрионов размножаться в крови с выделением экзотоксина
способность вибрионов вызывать интенсивное воспаление слизистой
65. Выберите вид клинического материала и основной метод лабораторной диагностики брюшного тифа на 1-ой неделе заболевания:
кровь, бактериологический
фекалии, бактериологический
серологический, РНГА
серологический, ИФА
серологический, РА Видаля
66. Брюшной тиф и паратифы относятся к инфекциям:
бактериальным, антропонозным
вирусным, зоонозным
бактериальным, зоонозным
бактериальным, сапронозным
вирусным, антропонозным
67. Сальмонеллезные пищевые токсикоинфекции относятся к:
бактериальным, антропонозным
вирусным, зоонозным
бактериальным, зооантропонозным
бактериальным, сапронозным
вирусным, антропонозным
68. Укажите механизм заражения брюшным тифом:
фекально-оральный
трансмиссивный
аэрозольный
крове-контактный
контактный
69. Escherichia coli принадлежит к семеству:
Clostridiaceae
Enterobacteriaceae
Vibrionaceae
Neisseriaceae
Bacillaceae
70. Укажите род энтеробактерий, включающий облигатных представителей нормальной микрофлоры кишечника человека:
Escherichia
Salmonella
Shigella
Proteus
Yersinia
71. Укажите, к какой группе по отношению к кислороду принадлежит Escherichia coli:
облигатные анаэробы
факультативные анаэробы
микроаэрофилы
строгие аэробы
аэротолерантные бактерии
72. Для выделения Escherichia coli из клинического материала используют:
среду Гисса
тиогликолевую среду
кровяной агар
среду Эндо
щелочной МПА
73. О-антиген эшерихий представляет собой:
гликопротеид
гликолипид
липополисахарид
липид
полипептид
74. О-антиген энтеробактерий входит в состав:
жгутиков
наружной мембраны клеточной стенки
цитоплазматической мембраны
капсулы
фимбрий
75. Н-антиген энтеробактерий входит в состав:
клеточной стенки
цитоплазматической мембраны
капсулы
пилей
жгутиков
76. Выберите основной метод лабораторной диагностики эшерихиозов:
бактериологический
микроскопический
серологический
биологический
аллергический
77. Патогенные эшерихии дифференцируют от условно-патогенных:
по цвету колоний на среде Эндо
по антигенным свойствам
по способности ферментировать лактозу
по тинкториальным признакам
по морфологическим признакам
78. Для серотипирования энтеробактерий используют:
реакцию агглютинации в пробирках
реакцию агглютинации на стекле
реакцию преципитации
метод иммунофлуоресценции
иммуноферментный анализ
79. Фактором, экранирующим О-антиген эшерихий в серологических реакциях, является:
Н-антиген
К-антиген
пептидогликан
фимбрии
белки наружной мембраны
80. Для выявления О-антигена эшерихий в РА предварительно необходимо:
экстрагировать О-антиген ацетоном
разрушить Vi-антиген кипячением
разрушить К-антиген кипячением
разрушить Н-антиген кипячением
нейтрализовать Vi-антиген сывороткой
81. Ферментация лактозы характерна для:
Escherichia coli
Shigella flexneri
Salmonella Typhi
Salmonella Typhimurium
Yersinia pestis
82. Клиника и патогенез заболеваний, вызванных энтеротоксигенными кишечными палочками, являются аналогичными клинике и патогенезу:
шигеллеза
брюшного тифа
сальмонеллезного гастроэнтерита
иерсиниоза
холеры
83. LT –токсин энтеротоксигенных эшерихий по механизму действия на клетку-мишень является:
активатором аденилатциклазной системы
ингибитором синтеза белка
блокатором передачи нервного импульса
эксфолиативным токсином
порообразующим токсином
84. Клиника и патогенез заболеваний, вызванных энтероинвазивными кишечными палочками, аналогичны клинике и патогенезу:
шигеллеза
брюшного тифа
сальмонеллезного гастроэнтерита
иерсиниоза
холеры
85. Специфическая профилактика эшерихиозов включает:
применение живых вакцин
применение химических вакцин
использование убитых вакцин
не разработана
применение анатоксина
86. Выберите верно указанные морфологические признаки эшерихий:
крупные, толстые палочки со спорами
мелкие, слегка изогнутые палочки, монотрихи
грамположительные кокки
грамотрицательные кокки
грамотрицательные палочки
87. Свойством Salmonella Typhi, ответственным за системные проявления инфекции является:
способность выживать в макрофагах
продукция экзотоксина А
подвижность
резистентность к лизиcу бактериофагами
устойчивость к действию антибиотиков
88. Какие микроорганизмы являются причиной развтия гемолитико-уремического синдрома?
Staphylococcus aureus
Escherichia coli (ЭГКП)
Gardnerella vaginalis
Chlamydia trachomatis
Vibrio cholerae
89. Что является важнейшей причиной летального исхода при брюшном тифе?
геморрагический некроз
токсинемия
лихорадка
синдром диссеминированного внутрисосудистого свертывания
диарея
90. Продолжительность инкубационного периода при дизентерии:
6 - 8 часов
24 - 48 часов
2 - 4 дня
1 - 2 недели
1-6 месяцев
91. Продолжительность инкубационного периода при брюшном тифе:
6 - 8 часов
24 - 48 часов
2 - 4 дня
1 - 2 недели
1-6 месяцев
92. Продолжительность инкубационного периода при стафилококковой интоксикации:
2 - 24 часов
3 - 4 дня
1 - 2 недели
3 - 4 недели
1 - 6 месяцев
93. Наиболее характерно для кишечной группы микроорганизмов проникновение в организм человека через:
поврежденную кожу
через слизистые ЖКТ
укусы насекомых
через слизистые дыхательного тракта
кровь
94. Наиболее характерно для кишечной группы микроорганизмов выделение из организма человека через:
фекалии
мокроту
грудное молоко
кожные покровы (потовые железы)
кровеносную систему
95. Укажите микроорганизмы, продуцирующие бактериальные токсины обладающие аналогичным механизмом действия:
Escherichia coli и Vibrio cholerae
Clostridium botulinum и Shigella sonnei
Bacteroides fragilis Campylobacter spp.
Salmonella Typhi и Clostridium perfringens
Staphylococcus aureus и Salmonella Typhi
96. Укажите какой из перечисленных микроорганизмов, вызывающих кишечные инфекции, является психрофилом:
Yersinia enterocolitica
Staphylococcus aureus
Campylobacter jejuni
Shigella sonnei
Escherichia coli
97. Какой тип эшерихий наиболее часто является причиной диареи, сопровождающейся появлением в фекалиях прожилок крови и лейкоцитов:
ЭПКП
ЭТКП
ЭИКП
ЭАГП
ЭГКП
98. Какой тип диареегенных эшерихий вызывает дизентериеподобное заболевание:
ЭПКП
ЭТКП
ЭИКП
ЭАГП
ЭГКП
99. Токсический эффект эндотоксина обусловлен присутствием в его составе:
липидного компонента
белковых молекул
углеводного компонента
нуклеиновых кислот
аминокислот
ВЫБЕРИТЕ ВСЕ ПРАВИЛЬНЫЕ ОТВЕТЫ
100. Как можно охарактеризовать иммунитет, формирующийся после перенесённой холеры?
антитоксический
антибактериальный
местный
типоспецифический
противовирусный
101. Какие заболевания могут вызываться представителями рода Salmonella?
брюшной тиф
дизентерия
язвенная болезнь желудка и двенадцатиперстной кишки
гастроэнтериты и энтероколиты
кишечный иерсиниоз
102. Какие заболевания могут вызываться Helicobacter pylori?
брюшной тиф
дизентерия
язвенная болезнь желудка и двенадцатиперстной кишки
хронический бактериальный гастрит
холера
103. Выберите черты, характеризующие представителей рода Shigella:
грам-отрицательный тип клеточной стенки
наличие эндотоксина
способность проникать в мезентериальные лимфоузлы и вызывать их воспаление
способность к инвазии в колоноциты и размножению в них
способность к распространению с током крови, находясь внутри макрофагов
104. Выберите черты, характеризующие Helicobacter pylori:
грам-отрицательный тип клеточной стенки
извитая форма, наличие жгутиков
способность проникать в мезентериальные лимфоузлы и вызывать их воспаление
способность к инвазии в колоноциты и размножению в них
способность защелачивать среду вокруг себя с помощью фермента уреазы
105. Какие методы микроскопии можно использовать для изучения подвижности холерного вибриона?
фазовоконтрастную микроскопию
темнопольную микроскопию
иммерсионную микроскопию
электронную микроскопию
люминесцентную микроскопию
106. Выберите серогруппы Vibrio cholera – возбудители холеры:
О1
О2
О101
О135
О139
107. Выберите биовары Vibrio cholera О1, имеющие эпидемическое значение:
Vibrio cholerae albensis
Vibrio cholerae cholerae
Vibrio cholerae Ogawa
Vibrio cholerae eltor
Vibrio cholerae Inaba
108. Выберите серовары Vibrio cholera серогрупы О1:
Hikojima
Cholerae
Ogawa
Eltor
Inaba
109. В ходе бактериологического исследования при холере подозрительные колонии проверяют в реакции:
агглютинации с О1 холерной сывороткой
агглютинации с О139 холерной сывороткой
непрямой гемагглютинации
обратной непрямой гемагглютинации
нейтрализации токсина
110. Действующим началом вакцины для профилактики холеры является:
О-антиген
капсульный полисахарид
фимбриальный антиген
Н-антиген
холероген-анатоксин
111. Для эшерихий характерно:
наличие тейхоевых кислот в клеточной стенке
наличие жгутиков
наличие пилей
наличие ЛПС в клеточной стенке
образование спор
112. Выберите основные антигены эшерихий:
капсульный К-антиген
белок А
О-антиген
Н-антиген
Vi-антиген
113. Выберите группы диареегенных Escherichia сoli:
энтеротоксигенные
уропатогенные
энтеропатогенные
энтероинвазивные
септицемические
114. Выберите группы диареегенных Escherichia сoli:
энтерогеморрагические
энтероаггрегативные
уропатогенные
энтеропатогенные
менингит-ассоциированные
115. Патогенез заболеваний, вызванных энтеротоксигенными эшерихиями характеризуется следующими признаками:
колонизация тонкого кишечника
колонизация толстого кишечника
продукция энтеротоксинов
вызывают холероподобную инфекцию
вызывают дизентериеподобную инфекцию
116. Выберите характеристики энтероинвазивных эшерихий:
основными факторами патогенности является комплекс белков, инъецируемых III типом секреции
вызывает холероподобное заболевание
локализация инфекционного процесса в толстом кишечнике
неподвижны, вызывают дизентериеподобную инфекцию
локализация инфекционного процесса в тонком кишечнике
117. Для энтеропатогенных эшерихий характерны следующие признаки:
колонизируют энтероциты тонкого и толстого кишечника
инвазируют энтероциты
имеют токсические белки, участвующие в адгезии, нарушении цитоскелета
характерна генерализация процесса
вызывают диарею у детей первого года жизни
118. Выберите верные утверждения об ЭПКП:
процесс адгезии и колонизации начинается с действия нейраминидазы
процесс адгезии и колонизации начинают пили IV типа
инъекционные токсические белки нарушают цитоскелет энтероцитов
при размножении происходит «сглаживание» микроворсинок
после адгезии ЭПКП проникают в эпителиоциты
119. Выберите верные утверждения об энтерогеморрагических эшерихиях:
способность к синтезу Шига-токсина и шигаподобных токсинов
основной путь предачи через пищевые продукты
вызывают дизентериеподобные заболевания
вызывают холероподобные заболевания
вызывают геморрагический колит, гемолитико-уремический синдром
120. Выберите питательную среду, позволяющую дифференцировать энтеробактери по биохимической активности:
среда Эндо
среда Плоскирева
среда Клиглера
висмут-сульфит агар
желточно-солевой агар
121. Выберите верные утверждения о системах секреции III типа:
представляют из себя белковые " инъекционные иглы", схожие по строению со жгутиками
способны транспортировать белки в цитоплазму эукариотических клеток
являются важными факторами патогенности сальмонелл и шигелл
являются важными факторами патогенности иерсиний и ЭПКП
являются важными факторами патогенности холерного вибриона и ЭТКП
122. Выберите подвижные микроорганизмы:
Vibrio cholerae
Helicobacter pylori
Campylobacter jejuni
Salmonella typhi
Shigella flexneri
123. Выберите факторы патогенности Salmonella Typhi:
эндотоксин
Vi-антиген
фимбриальные белки
лейкоцидин
инъекционные белки, секретируемые по III типу
124. Выберите факторы патогенности Shigella spp.:
инъекционные белки, секретируемые по III типу
Шига и шигаподобные токсины
фимбриальные и афимбриальные белки наружной мембраны
лейкоцидин
эндотоксин
125. Выберите факторы патогенности Yersinia enterocolitica:
термостабильный энтеротоксин
нейротоксин
инъекционные белки, секретируемые по III типу
эндотоксин
фимбриальные белки
126. Выберите факторы патогенности Campylobacter jejuni:
цитотоксин
нейротоксин
белки наружной мембраны
термолабильный энтеротоксин
эндотоксин
127. Выберите факторы патогенности Helicobacter pylori:
экзотоксин-суперантиген
протеазы (муциназа)
эндотоксин
цитотоксин
уреаза
128. Выберите питательные среды, на которых можно дифференцировать бактерии по способности ферментировать лактозу:
мясо-пептонный агар
щелочной пептонный агар
среда Плоскирева
среда Эндо
среда Левина
129. По каким признакам могут быть дифференцированы представители энтеробактерий внутри семейства Enterobacteriaceae:
ферментация углеводов
продукция сероводорода
реакция на индол
каталазный тест
оксидазный тест
130. Для каких инфекций животные могут быть источником и резервуаром в природе:
брюшной тиф
геморрагический колит (ЭГКП)
сальмонеллез (Salmonella enteritidis)
холера (Vibrio cholerae)
кампилобактериоз (Campylobacter spp.)
131. Campylobacter обладает следующими свойствами:
хорошо растет при 42 C на селективных средах, содержащих антибиотики
хорошо растет при 26 С на простых питательных средах
является грамотрицательным, имеет жгутики, лучше всего растет в атмосфере с низкой концентрацией кислорода и с добавлением СО2
потребление мяса птицы является наиболее частой причиной развития кампилобактериозной инфекции
лечение антибиотиками обычно не применяется
132. Выберите возбудителей заболеваний, при которых для профилактики и лечения необходимо создание как антибактериального, так и антитоксического иммунитета:
Campylobacter jejuni
Salmonella Typhi
Escherichia coli (ЭПКП)
Clostridium botulinum
Vibrio cholerae
133. Какие микрооппппппрганизмы могут являться причиной пищевого отравления?
Campylobacter jejuni
Salmonella enteriditis
Escherichia coli
Clostridium botulinum
Clostridium tetani
134. Какие микроорганизмы, вызывающие кишечные инфекции, не повреждают эпителиоциты и не вызывают изменения их морфологии?
ЭПКП
ЭТКП
ЭИКП
Shigella sonnei
Vibrio cholerae